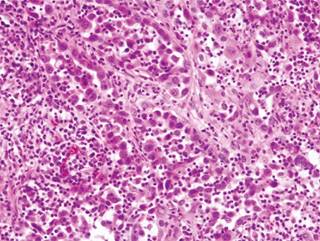

Introducción
Las metástasis vertebrales representan un desafío clínico y quirúrgico al comprometer la estabilidad y funcionalidad de la columna vertebral, asociando con relativa frecuencia un deterioro progresivo de la calidad de vida.1 Entre 8 y 24% de estas lesiones provienen de un tumor primario desconocido.2,3,4
La correcta evaluación del tumor y selección del paciente son esenciales para ofrecer el mejor tratamiento, en ocasiones combinando tratamientos médicos, quirúrgicos y radioterapéuticos.5 En este contexto, la vertebrectomía total emerge como una opción quirúrgica agresiva, pero capaz de alargar la supervivencia del paciente y ofrecer resultados funcionales favorables.6
En este artículo describimos un caso de metástasis vertebral de origen desconocido tratado mediante vertebrectomía total, además se presenta una revisión de la literatura.
Caso clínico
Varón de 46 años, fumador de un paquete al día y sin antecedentes médico-quirúrgicos de interés, que acude a consultas de nuestro centro por dolor cervical y lumbar que no cede con analgesia convencional. El dolor ha empeorado progresivamente, siendo éste de aparición lenta y gradual y de características inflamatorias. El paciente no presenta síndrome constitucional u otros signos de alarma. En la exploración física destaca dolor a la espinopresión de primeras vértebras torácicas y lumbares, sin déficits sensitivo-motores asociados.
Pruebas diagnósticas
El paciente aporta una tomografía axial computarizada (TAC) y una resonancia magnética nuclear (RMN) (Figuras 1 y 2) que muestran una lesión lítica inespecífica en la espinosa de T1 y otra lesión en el cuerpo vertebral de L2. Ante estos hallazgos, se solicita una gammagrafía y una TAC toracoabdominal y se reprograma al paciente en una semana en consultas. Se realiza la gammagrafía que sólo muestra captación a nivel de ambas lesiones vertebrales. La TAC toracoabdominal informa de un enfisema paraseptal con atelectasias en el lóbulo inferior derecho y un área inespecífica en vidrio deslustrado en el lóbulo medio, sin alteraciones en el parénquima pulmonar ni otras lesiones a nivel abdominal.

Figura 1: Tomografía axial computarizada (TAC) axial que muestra lesión lítica en apófisis espinosa de T1.

Figura 2: A y B) Cortes de resonancia magnética nuclear (RMN) sagital en T1 y STIR que muestran una masa tumoral en el cuerpo vertebral de L2. C) Corte de RMN en axial que evidencia la invasión tumoral del hemicuerpo izquierdo de L2.
Dados los hallazgos y la alta sospecha de lesión tumoral, se realiza una biopsia guiada por TAC de la espinosa de T1 y del cuerpo vertebral de L2, siendo el resultado de estas biopsias negativo. Se decide programar una biopsia abierta en quirófano bajo control por escopía, siendo compatible el resultado en esta ocasión con el de un adenocarcinoma pulmonar (Figura 3).
Figura 3: Imagen de la anatomía patológica del paciente. Se observan células grandes con pleomorfismo celular y nuclear. El estudio inmunohistoquímico reveló que las células expresaban queratinas AE1-AE3, CAM 5.2 y sobreexpresión de p53, lo que sugiere un tumor primario pulmonar.
Tras comentarse el caso en el Comité Multidisciplinar de Tumores se amplía el estudio con un PET-TAC, que informa nuevamente sobre la presencia de lesiones metastásicas en la apófisis espinosa de T1 y en el hemicuerpo izquierdo de L2, sin evidenciarse patología tumoral metabólicamente activa en otras localizaciones. También se realiza una analítica sanguínea que muestra elevación de los marcadores tumorales CEA y CA-125, siendo normales los valores de antígeno prostático específico (PSA).
Por lo tanto, se clasifica al tumor como un carcinoma indiferenciado de pulmón TxNxM1b por la presencia de metástasis vertebrales. Con un estadiaje según Tokuhashi de 7 puntos,7,8 la opción más apropiada es la cirugía paliativa; no obstante, se opta por llevar a cabo una cirugía excisional, alternativa que puede considerarse en ciertas situaciones específicas como la presencia de metástasis únicas sin afectación de órganos internos.
Operación y evolución postoperatoria
Se intervino la vértebra L2 en un solo tiempo por vía posterior mediante la técnica de Tomita (Figura 4).7 En un segundo procedimiento, que tuvo lugar un mes y medio después de la primera intervención, se resecó parcialmente el arco posterior (base de la apófisis espinosa y espinosa) de T1 (Figura 5). Un mes después de la cirugía se inicia radioterapia dirigida sobre las áreas metastásicas; se realizan 10 sesiones con un campo radioterápico de C7 a T2 y de L1 a L3, con una dosis de 3 Gy/sesión hasta alcanzar una dosis total de 30 Gy.

Figura 4: A y B) Imágenes intraoperatorias donde se observa la vertebrectomía de L2 junto a la artrodesis de T11 hasta L4. C y D) Radiografías de control, en las que puede observarse la artrodesis y la implantación de un cajón intersomático relleno de injerto óseo a nivel de L2.
El paciente es seguido conjuntamente por las unidades de traumatología, oncología, radioterapia, anestesia del dolor y psicología. A los seis años postoperatorios la enfermedad tumoral está estable, sin evidencia de tumor primario y sin signos de recidiva tumoral. El paciente presenta un empeoramiento de su dolor dorsolumbar, por lo que se realiza una TAC donde se observan signos de aflojamiento en el material de artrodesis y la rotura de los tornillos de L3 y L4.
Se procede a la revisión quirúrgica, retirándose el material y realizándose una ampliación de la artrodesis desde los niveles T11 hasta L5. También se obtienen cinco muestras que se envían a analizar al laboratorio de microbiología y una muestra al laboratorio de anatomía patológica. El servicio de patología no encuentra células tumorales en la muestra remitida, pero los cultivos resultan ser positivos para Propionibacterium acnes, iniciándose tratamiento antibiótico dirigido contra dicho germen.
En el postoperatorio se observa una dehiscencia de herida quirúrgica, por lo que se decide reintervenir al paciente y realizar un desbridamiento quirúrgico hasta plano muscular profundo. En esta reintervención los cultivos son negativos y, bajo la recomendación del servicio de enfermedades infecciosas, se inicia tratamiento antibiótico dirigido con imipenem.
Dos meses más tarde, el paciente requiere ser reintervenido por nueva dehiscencia de la herida; en esta ocasión, aparte de un exhaustivo desbridamiento quirúrgico, se recambia el material de artrodesis desde T11 hasta L5 y se realiza un colgajo de Keystone en la zona afecta con la colaboración del servicio de cirugía plástica (Figura 6). Finalmente, dada una buena evolución en planta de hospitalización convencional, el paciente es dado de alta y realiza seis semanas de terapia antibiótica oral con amoxicilina-clavulánico.

Figura 6: Imágenes intraoperatorias de la cobertura con el colgajo de Keystone para la zona afecta. El flap muscular se avanza desde la fascia para evitar comprometer la vitalidad del colgajo. A los extremos se realiza una forma de VY para disminuir la tensión durante el cierre.
Tras este episodio, el paciente continúa realizando seguimiento en consultas externas de traumatología, oncología, enfermedades infecciosas y anestesia para control del dolor. Diez años después del diagnóstico inicial de metástasis vertebral, dada la estabilidad clínica y la ausencia de tumor primario o signos de recidiva tumoral, el paciente es dado de alta de oncología considerándose libre de enfermedad tumoral. En la actualidad, sigue realizando controles anuales en nuestro servicio, con buenos resultados radiográficos y dolor lumbar controlado.
Discusión
Aproximadamente entre 8 y 24% de los pacientes que desarrollan metástasis en la columna vertebral tienen un tumor primario desconocido.2,3,4 Este diagnóstico se asocia a una baja supervivencia y a una mala calidad funcional,1 secundaria al dolor o a las posibles complicaciones neurológicas asociadas. Con esto, el objetivo principal ante esta entidad es mejorar la calidad de vida, bien mediante cirugía o radioterapia,5 siendo fundamental estimar la supervivencia del paciente para elegir el tratamiento que más se adapte a sus condiciones.
En este sentido el sistema de puntuación revisada de Tokuhashi y la puntuación de Tomita son los métodos más utilizados históricamente para predecir el pronóstico en pacientes con metástasis medulares,8,9 incluyendo aquellos casos en los que se desconoce el tumor primario.
Tokuhashi propuso un sistema de puntuación basado en puntuaciones individuales en seis categorías diferentes (Tabla 1), con el que se estima una puntuación en la que los pacientes con ocho o menos puntos son candidatos a un tratamiento conservador (bien sea radioterapia, quimioterapia, terapia hormonal o manejo del dolor) y los pacientes con una puntuación total de 12 o más son tributarios a una cirugía escisional. En aquellos casos, como el que hemos presentado, en que la puntuación total es de nueve a 11 se puede plantear una cirugía de escisión ante la presencia de una metástasis vertebral única sin afectación de órganos internos o una cirugía paliativa en la gran mayoría de pacientes que no cumplen estos criterios. Por lo tanto, el paciente que presentamos era un caso borderline para una cirugía escisional, pero dada la edad y el buen estado general del paciente se consideró que se le podía ofrecer este tratamiento.
Tabla 1: Escala pronóstica de Tokuhashi.
| Categoría y opciones | Puntuación |
|---|---|
| Estado general (índice de Karnofsky) | |
| Pobre (10-40) | 0 |
| Justo (50-70) | 1 |
| Bueno (80-100) | 2 |
| Número de metástasis óseas extravertebrales | |
| ≥ 3 | 0 |
| 1-2 | 1 |
| 0 | 2 |
| Número de metástasis vertebrales | |
| ≥ 3 | 0 |
| 2 | 1 |
| 1 | 2 |
| Número de metástasis en órganos internos | |
| Irresecable | 0 |
| Resecable | 1 |
| Ninguna | 2 |
| Localización de tumor primario | |
| Pulmón, estómago | 0 |
| Riñón, hígado, útero | 1 |
| Tiroides, próstata, mama, recto | 2 |
| Lesión medular (escala de Frankel) | |
| Completa | 0 |
| Incompleta | 1 |
| Ninguna | 2 |
Además de estos dos sistemas de puntuación, en los últimos años se han desarrollado nuevos modelos pronósticos para predecir la supervivencia en metástasis vertebrales;10 algunos de ellos incluso específicos para metástasis con tumor primario desconocido.11 Pero hasta la fecha, todos estos sistemas carecen de un proceso de validación estadísticamente preciso y es por esto que siguen utilizándose los sistemas de puntuación convencionales.
En lo que respecta al tratamiento de las metástasis vertebrales, existen varias opciones que deben individualizarse según los síntomas del paciente (compresión medular, inestabilidad vertebral, dolor…), el número y localización de las metástasis vertebrales, la radiosensibilidad del tumor, el pronóstico y la edad del paciente, entre otros.12 El abanico de opciones terapéuticas incluye, pues, el uso de ortesis externas para prevenir o tratar fracturas vertebrales, la farmacoterapia (de utilidad en tumores hormonosensibles), la radioterapia o la cirugía,13 pudiendo utilizarse una o varias estrategias de tratamiento de forma simultánea o secuencial.
Los principales objetivos del tratamiento quirúrgico serán reducir el volumen tumoral, resecar las estructuras en contacto con el canal medular (laminectomía o hemifacetectomía) para minimizar el riesgo de lesión nerviosa y/o compresión medular y, secundariamente, estabilizar la columna, permitiendo así la movilización del paciente sin la ayuda de una órtesis externa.14
En aquellos casos, como nuestro paciente, que presentan una o dos metástasis vertebrales y se acompañan de un buen estado de salud general y esperanza de vida, el procedimiento indicado será la resección tumoral ventral6 (vertebrectomía total) e instrumentación estabilizadora primaria. Debe mencionarse que dada la complejidad de la anatomía vertebral es recomendable asociar este procedimiento con la radioterapia postoperatoria para asegurar la completa remisión del tumor. La radioterapia preoperatoria, en cambio, no debe plantearse dado que puede dar problemas en la cicatrización de las heridas quirúrgicas.15
Esta técnica fue descrita por primera vez por Enneking y colaboradores16 a propósito de un caso de resección tumoral de un osteosarcoma espinal y posteriormente acuñado por Tomita.17 Únicamente se utiliza para tumores en cuerpo vertebral y consiste en una laminectomía y vertebrectomía en bloque hasta tejido sano adyacente seguido de una instrumentación posterior para reconstruir la columna.18
Desde su primera descripción, se ha empleado cada vez con mejores resultados quirúrgicos,19,20 aunque la relativa complejidad de esta técnica conlleva que gran parte de la literatura consista en series de casos. Está indicada para tumores primarios malignos, tumores benignos agresivos y para lesiones metastásicas solitarias,19 y ha demostrado su eficacia para mejorar el pronóstico de los tumores óseos primarios de la columna vertebral21 y la calidad de vida de los pacientes con metástasis aisladas. Sin embargo, esta técnica también se asocia a una alta morbilidad que puede afectar la calidad de vida del paciente y que debería tenerse en cuenta en el momento de planificar la cirugía.22
Boriani asociados22 reportaron 35.1% de complicaciones postquirúrgicas en su estudio publicado en el año 2010, en el que fueron incluidos un total de 134 pacientes (con tumor primario o metástasis vertebral) a los que se realizó una vertebrectomía total. Tres pacientes (2%) fallecieron por complicaciones mientras que diez (7%) precisaron de una cirugía de revisión por fracaso de la instrumentación. La mayoría de complicaciones se asociaron a la alta complejidad de la técnica (lesión del plexo epidural, de raíces nerviosas, etcétera), al largo tiempo quirúrgico (dehiscencia de herida, infecciones, etcétera) o fueron complicaciones de carácter más tardío, como el aflojamiento mecánico de la instrumentación vertebral. Aun así, la mitad de los pacientes (13/27 = 48.1%) que sufrieron una complicación grave seguían vivos y con un excelente estado funcional tras 25-160 meses de seguimiento, lo que parece justificar la realización de un procedimiento quirúrgico tan agresivo.
En resumen, la morbilidad de esta técnica debe equilibrarse con la posibilidad de conceder una larga supervivencia con una excelente calidad de vida.18,20,21,22 Casos como el de nuestro paciente parecen estar justificados dado que, más de una década más tarde del diagnóstico inicial, nuestro paciente se encuentra libre de enfermedad y con un adecuado control del dolor lumbar.
Conclusión
La vertebrectomía total es una técnica quirúrgica de gran utilidad en el tratamiento tanto de tumores primarios como de metástasis vertebrales únicas, habiendo demostrado resultados funcionales favorables a largo plazo. Sin embargo, dada la alta incidencia de complicaciones, es crucial emplear sistemas de puntuación pronóstica como el de Tokuhashi para identificar a los pacientes que más puedan beneficiarse con esta cirugía y combinar esta técnica con otras líneas terapéuticas, como la radioterapia o la hormonoterapia, para ofrecer mejores resultados.











 nueva página del texto (beta)
nueva página del texto (beta)



